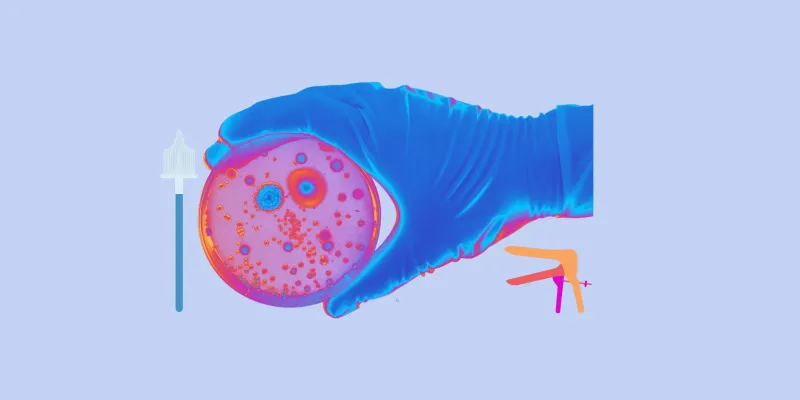

Η καλλιέργεια κολπικού υγρού είναι μια απλή εξέταση που έχει ως στόχο την ανίχνευση και ταυτοποίηση μικροοργανισμών, όπως βακτήρια και μύκητες, που μπορεί να προκαλούν λοιμώξεις στον κόλπο (κολπίτιδα) και τον τράχηλο της μήτρας (τραχηλίτιδα). Η εξέταση συστήνεται ιδιαίτερα σε περιπτώσεις όπου υπάρχουν συμπτώματα όπως αλλαγές στις κολπικές εκκρίσεις, πόνος, κνησμός ή άλλα σημάδια λοίμωξης.
Συμπτώματα που Υποδηλώνουν την Ανάγκη για Καλλιέργεια
- ✔ Ασυνήθιστες Κολπικές Εκκρίσεις: Εκκρίσεις με ασυνήθιστο χρώμα (λευκό, κίτρινο, πράσινο) ή ποσότητα.
- ✔ Πόνος ή Ερεθισμός στην κολπική περιοχή.
- ✔ Κακοσμία των Κολπικών Εκκρίσεων: Ισχυρή και δυσάρεστη οσμή.
- ✔ Παρουσία Κνησμού και Ερεθισμού στα έξω γεννητικά όργανα.
Μια απλή καλλιέργεια μπορεί να ανιχνεύσει λοιμώξεις που αν αφεθούν χωρίς θεραπεία, μπορεί να προκαλέσουν σοβαρές επιπλοκές, όπως φλεγμονώδη νόσο της πυέλου ή υπογονιμότητα.
Η Καλλιεργεια Κολπικου Υγρου γίνεται και για την πρόληψη των Σεξουαλικά Μεταδιδόμενων Νοσημάτων
❓ Δεν είστε σίγουρη αν χρειάζεστε Καλλιέργεια Κολπικού Υγρού;
Κάντε ένα σύντομο quiz και δείτε αν τα συμπτώματά σας δείχνουν ότι χρειάζεστε εξέταση, ενημέρωση ή απλώς προληπτικό έλεγχο.
Η εξέταση πραγματοποιείται στο ιατρείο μας κατόπιν ραντεβού.
Κόστος από 30 έως 60 ευρώ για μια πλήρη καλλιέργεια, με αποτελέσματα συνήθως μέσα σε 3 ημέρες.
Αν δεν είστε σίγουρες αν τη χρειάζεστε, μπορούμε να συζητήσουμε πρώτα τα συμπτώματά σας.
Άλλες Καταστάσεις που Χρειάζεται να Γίνει Καλλιέργεια Κολπικού Υγρού
✔ Βακτηριακή Κολπίτιδα:
- Έλεγχος για βακτηριακή κολπίτιδα (Gardnerella Vaginalis), μια κοινή λοίμωξη που σχετίζεται με διαταραχή στη φυσική κολπική χλωρίδα.
✔ ASCUS στο Τεστ Παπανικολάου:
- Σε περιπτώσεις όπου το τεστ Παπ δείχνει άτυπα κύτταρα, μια καλλιέργεια μπορεί να αποκαλύψει πρόσθετες πληροφορίες.
✔ Γυναίκες που επιθυμούν εγκυμοσύνη:
- Γυναίκες που θέλουν να ξεκινήσουν προσπάθειες για εγκυμοσύνη ξέρουμε οτι μπορεί μια κολπίτιδα να επηρεάσει τη γονιμότητα τους.
✔ Προληπτικός Έλεγχος για Σεξουαλικά Μεταδιδόμενα Νοσήματα (ΣΜΝ):
- Γυναίκες που επιθυμούν προληπτικό έλεγχο για ΣΜΝ μπορούν να υποβληθούν σε καλλιέργεια ακόμη και χωρίς την παρουσία συμπτωμάτων.
✔ Εγκυμοσύνη:
- Η καλλιέργεια κολπικού υγρού στην εγκυμοσύνη ανιχνεύει μικροοργανισμούς, όπως τον στρεπτόκοκκο ομάδας Β, που μπορεί να προκαλέσει επιπλοκές στη μητέρα και το μωρό στον τοκετό.

Κοινές Λοιμώξεις Που Ανιχνεύονται Μέσω της Καλλιέργειας Κολπικού Υγρού
Η καλλιέργεια κολπικού υγρού μπορεί να ανιχνεύσει μια πληθώρα κοινών λοιμώξεων.
| Μικροοργανισμός | Χαρακτηριστικά |
|---|---|
| Βακτηριακή Κολπίτιδα (Gardnerella Vaginalis) | Διαταραχή της κολπικής χλωρίδας |
| Καντιντίαση (Μυκητιασική κολπίτιδα) | Λοίμωξη που προκαλείται από μύκητες, συνήθως του γένους Candida |
| Χλαμύδια (Chlamydia Trachomatis) | Μπορεί να προκαλέσει υπογονιμότητα |
| Γονόρροια (Neisseria gonorrhoeae) | Το πιο συχνό ΣΜΝ |
| Ουρεόπλασμα (Ureaplasma Urealyticum) | Μπορεί να προκαλέσει αποβολή ή πρόωρο τοκετό |
| Μυκόπλασμα (Mycoplasma Genitalium) | Προκαλεί ουρηθρήτιδα και πυελική φλεγμονή |
| Τριχομονίαση | Σεξουαλικά μεταδιδόμενη λοίμωξη που προκαλείται από το παράσιτο Trichomonas vaginalis |
| Λοιμώξεις από άλλα Βακτήρια | Staphylococcus, E. Coli και Klebsiella spp. |
Πώς Γίνεται η Καλλιεργεια Κολπικου Υγρου;
Η καλλιέργεια πραγματοποιείται με τη λήψη δείγματος με μια μπατονέτα από τον κόλπο ή/και τον τράχηλο της μήτρας. Η διαδικασία είναι ίδια με αυτή του Τεστ Παπ. Αυτό το δείγμα στη συνέχεια αναλύεται στο εργαστήριο, όπου παρακολουθείται για την ανάπτυξη βακτηρίων, ιών ή μυκήτων.
Πώς να Προετοιμαστείτε για την Εξέταση;
Δεν χρειάζεται κάποια ιδιαίτερη προετοιμασία για την εξέταση. Καλό θα είναι να μην έχει γίνει πρόσφατη χρήση κάποιου κολπικού σκευάσματος που μπορεί να αλλοιώσει τα αποτελέσματα.
Σε πόσο καιρό βγαίνουν τα αποτελέσματα;
Τα αποτελέσματα συνήθως βγαίνουν μετά από 3 ημέρες. Κάποια μικρόβια, όμως, μπορεί να χρειάζονται περισσότερο χρόνο για να αποκαλυφθούν στην καλλιέργεια.
Τι σημαίνουν τα αποτελέσματα της Καλλιέργειας Κολπικού Υγρού;
Εάν η καλλιέργεια κολπικού υγρού είναι αρνητική αυτό σημαίνει ότι δεν αναπτύχθηκε κάποιο μικρόβιο από αυτά που ελέγχθηκαν. Στην περίπτωση που βρεθεί κάποιο μικρόβιο αυτό θα πρέπει να συνοδεύεται πάντα από το αντιβιόγραμμα το οποίο μας δείχνει ποια αντιβιοτικά μπορούν να αντιμετωπίσουν το συγκεκριμένο μικρόβιο και θα καθορίσει τη διάρκεια της θεραπείας.
Ποιο είναι το κόστος της Καλλιέργειας Κολπικού Υγρού;
Το κόστος της καλλιέργειας κολπικού υγρού μπορεί να κυμαίνεται ανάλογα με τα μικρόβια που θέλουμε να εξετάσουμε. Πρόκειται για μια απλή εξέταση που μπορεί να σας γλιτώσει από σοβαρότερα προβλήματα υγείας. Στο ιατρείο μας, οι τιμές κυμαίνονται μεταξύ 30 και 60 ευρώ για μια πλήρη καλλιέργεια και μπορείτε να κλείσετε το ραντεβού σας εύκολα ONLINE.
Πώς θα σας βοηθήσουμε;
Καταλαβαίνουμε ότι τα αποτελέσματα μιας καλλιέργειας μπορεί κάποιες φορές να φαίνονται πολύπλοκα. Είμαστε εδώ για να σας εξηγήσουμε τα αποτελέσματα και να σας καθοδηγήσουμε στη σωστή θεραπεία χωρίς άγχος. Αν έχετε απορίες ή χρειάζεστε περαιτέρω διευκρινίσεις, επικοινωνήστε μαζί μας για να βρούμε μαζί τις απαντήσεις που χρειάζεστε.
Συχνές Ερωτήσεις
Πόσο συχνά πρέπει να γίνεται η καλλιέργεια εάν δεν υπάρχουν συμπτώματα;
Μπορεί μια λοίμωξη να επανεμφανιστεί μετά τη θεραπεία;
Πώς μπορεί μια λοίμωξη να επηρεάσει τη γονιμότητα;
Πρέπει να ενημερώσω τον σύντροφό μου αν τα αποτελέσματα δείξουν λοίμωξη;
Εξετάζουμε καθημερινά γυναίκες με συμπτώματα όπως αυτά που περιγράψαμε.
Η καλλιέργεια κολπικού υγρού μπορεί να σας δώσει απαντήσεις και λύσεις.
Το ραντεβού διαρκεί λίγα λεπτά και τα αποτελέσματα βγαίνουν συνήθως σε 3 ημέρες.
Πηγές
Money D. The laboratory diagnosis of bacterial vaginosis. Can J Infect Dis Med Microbiol. 2005;16(2):77-79. doi:10.1155/2005/230319 https://www.cdc.gov/std/treatment-guidelines/candidiasis.htm









